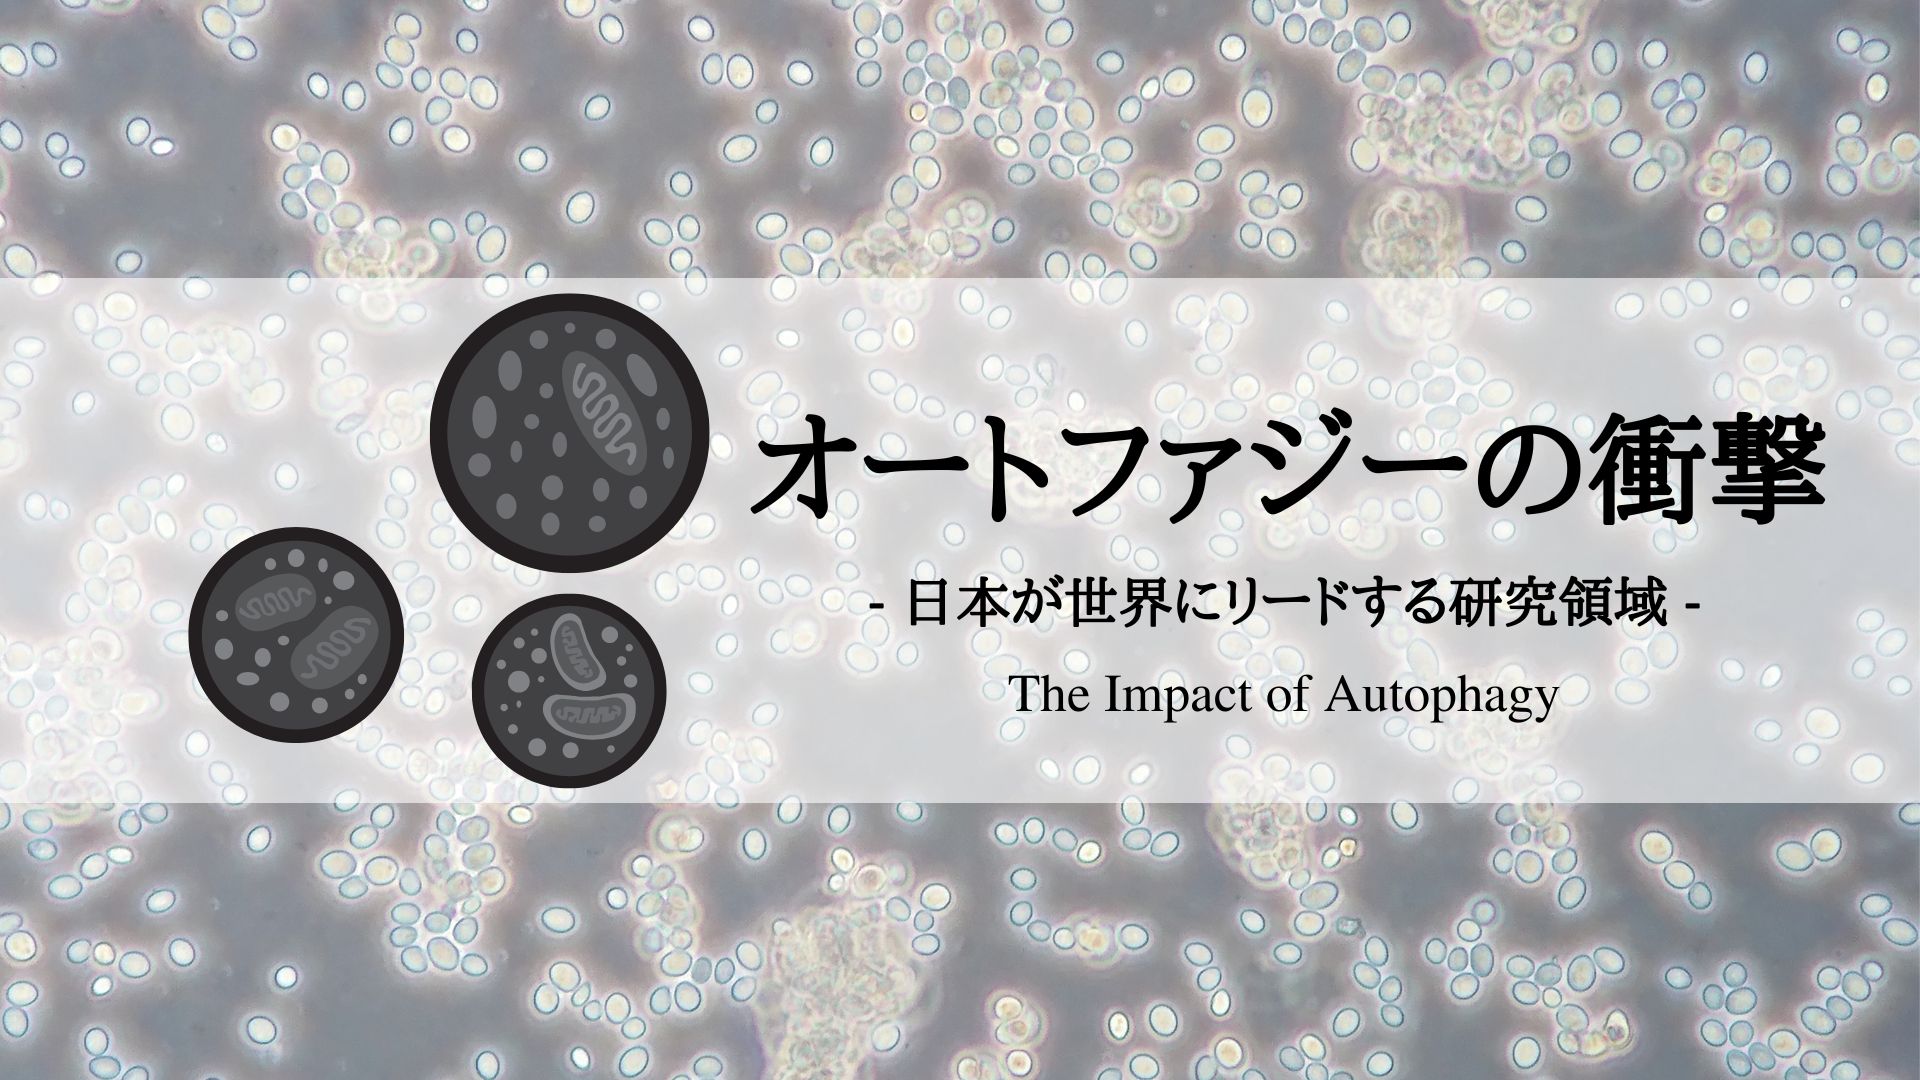

細胞が自らを分解・再生する驚異の仕組み「オートファジー」。大隅良典氏のノーベル賞受賞に象徴されるように、日本はこの分野の基礎研究から応用研究まで世界をリードしてきた。老化や神経変性疾患、がん治療など医療への応用も進む今、最先端の研究から生命の本質に迫り、日本発の画期的な成果と未来への可能性を解説する。




1. オートファジーとは?
オートファジー(自食作用)とは、細胞が自らの内部構造やタンパク質を分解・再利用する仕組みです (Autophagy – Wikipedia) (Autophagy – Wikipedia)。主な形式としてマクロオートファジー(一般的に「オートファジー」と言えばこちら)とシャペロン介在性オートファジー(CMA)の2種類があります(他にミクロオートファジー等も存在) (Autophagy – Wikipedia) (Autophagy – Wikipedia)。
マクロオートファジーでは、まず細胞質内に隔離膜(ファゴフォア)が出現し、不要なタンパク質や壊れた細胞小器官(ミトコンドリアなど)を包み込んで二重膜小胞のオートファゴソームを形成します (Figure 1, Schematic diagram of the steps of autophagy. – WormBook – NCBI Bookshelf)。次にオートファゴソームがリソソームと融合してオートリソソーム(またはオートファゴリソソーム)となり、内部の物質が加水分解酵素によって分解・消化され、アミノ酸など基本構成単位に再生されます (Figure 1, Schematic diagram of the steps of autophagy. – WormBook – NCBI Bookshelf)。この一連の過程により、細胞は飢餓時に栄養源を確保し、平常時にも不要物の除去や細胞内恒常性の維持を行います (Autophagy – Wikipedia) (Autophagy – Wikipedia)。
(Figure 1, Schematic diagram of the steps of autophagy. – WormBook – NCBI Bookshelf) 図1: マクロオートファジーの段階。隔離膜(isolation membrane)が出現し(Vesicle nucleation)、膜が拡大してオートファゴソームを形成(Vesicle elongation)。オートファゴソームがリソソームと融合して内容物を消化するオートリソソーム(Autolysosome)となり、最終的に内部の構成物が分解・再利用される(Vesicle breakdown & degradation) (Figure 1, Schematic diagram of the steps of autophagy. – WormBook – NCBI Bookshelf)。
一方、**シャペロン介在性オートファジー(CMA)**はマクロオートファジーとは異なる選択的な分解経路です (Autophagy – Wikipedia)。CMAでは分解すべきタンパク質自身が特定のアミノ酸配列(KFERQモチーフ)を持ち、それを認識した細胞質シャペロン(Hsc70)により直接リソソーム膜上の受容体タンパク質LAMP2Aへと送り込まれます (Autophagy – Wikipedia)。基質タンパク質はリソソーム膜上で展開(アンフォールド)され、1つずつリソソーム内部へ移送されてリソソーム内の酵素で分解されます (Autophagy – Wikipedia)。つまりCMAではオートファゴソームは介さず、特定のタンパク質だけをピンポイントで処理する点で、まとめて構造物を包み込むマクロオートファジーと大きく異なります (Autophagy – Wikipedia)。
(File:Autophagy.jpg – Wikimedia Commons) 図2: マクロオートファジーとシャペロン介在性オートファジー(CMA)の模式図(パーキンソン病におけるαシヌクレイン分解経路の例) (File:Autophagy.jpg – Wikimedia Commons)。左上:マクロオートファジーでは不溶性のタンパク質凝集体や不要な細胞小器官(ミトコンドリアなど)をオートファゴソームで取り込み分解する。右下:CMAではHsc70シャペロンが標的タンパク質(例:αシヌクレイン)の特定配列を認識し、LAMP2A受容体を介してリソソーム内に1つずつ輸送して分解する。変異型αシヌクレイン(A53TやA30P)はCMAでの分解が阻害され、結果的にマクロオートファジーにより処理されることが知られている (File:Autophagy.jpg – Wikimedia Commons)。
オートファジーの概念自体は1960年代には顕微鏡観察で提唱されていましたが、その分子メカニズムは長らく謎でした (世界中が注目 ノーベル賞受賞の「オートファジー」 – ResOU)。この「長い眠り」を醒まし、オートファジー研究を飛躍させたのが日本の分子生物学者、大隅良典氏です。大隅氏は1980年代から誰も注目していなかった酵母の液胞(動物細胞のリソソームに相当)に着目し、1992年に酵母細胞でオートファジー現象を世界で初めて光学顕微鏡下に捉えることに成功しました (オートファジー-ノーベル賞を受賞した大隅栄誉教授の研究とは | 東工大ニュース | 東京工業大学) (オートファジー-ノーベル賞を受賞した大隅栄誉教授の研究とは | 東工大ニュース | 東京工業大学)。さらに独自のスクリーニング手法で「オートファジーが起こらない」変異株を探し出し、1993年までにオートファジーに必須な遺伝子群(ATG遺伝子)14個を同定したのです (オートファジー-ノーベル賞を受賞した大隅栄誉教授の研究とは | 東工大ニュース | 東京工業大学) (オートファジー-ノーベル賞を受賞した大隅栄誉教授の研究とは | 東工大ニュース | 東京工業大学)(後にATG遺伝子は18種類に拡大)。この酵母を用いた画期的な発見により、オートファジーの分子機構が一気に解明され、細胞生物学の新たな地平が拓かれました (世界中が注目 ノーベル賞受賞の「オートファジー」 – ResOU)。大隅氏の功績は世界的に高く評価され、2016年ノーベル生理学・医学賞が「オートファジーの仕組みの解明」に対して単独授与されています (Autophagy – Wikipedia)。これは細胞内のリサイクル機構の重要性を示す歴史的偉業であり、日本発の基礎研究が世界をリードした象徴的な出来事と言えるでしょう。
2. 日本がリードするオートファジー研究
オートファジー研究の分野では、日本の研究機関・大学がこれまで大きな役割を果たしてきました。大隅良典氏の先駆的な発見を皮切りに、日本からは数多くの優れた研究成果が生み出されています。
例えば、東京大学の水島昇教授や大阪大学の吉森保教授は、哺乳類におけるオートファジー研究を世界最先端で牽引してきた研究者です。水島・吉森両氏はマウスでオートファジーを可視化するGFP-LC3マウスの開発や、オートファジーの生理的役割の解明などで顕著な功績を収め、2015年には「哺乳類オートファジーの分子機構と生理機能の研究」により共同で上原賞を受賞しています (世界中が注目 ノーベル賞受賞の「オートファジー」 – ResOU)。吉森氏は大隅氏の下で基礎生物学研究所(岡崎)に勤務した経歴を持ち、オートファジーがうまく働かないとパーキンソン病・アルツハイマー病・糖尿病など様々な疾患を引き起こし得ることをいち早く指摘するなど (世界中が注目 ノーベル賞受賞の「オートファジー」 – ResOU)、哺乳類オートファジーの役割と病気との関連について世界をリードする研究を展開しています (世界中が注目 ノーベル賞受賞の「オートファジー」 – ResOU)。一方、水島氏はオートファジー関連タンパク質LC3の発見や、選択的オートファジー(後述)の分子基盤解明など基礎的理解に貢献しつつ、近年では新規の分解経路の発見にも取り組んでいます。
日本の研究グループによる最新成果の一例として、東京大学の水島教授らが2019年に報告した、小胞体(ER)選択的オートファジーの新規受容体タンパク質TEX264の発見が挙げられます (共同発表:オートファジーによる小胞体分解の新規受容体を発見) (共同発表:オートファジーによる小胞体分解の新規受容体を発見)。従来、オートファジーは不特定多数の構成要素を一括分解する非選択的プロセスと考えられてきましたが、実際には損傷を受けた細胞小器官や不要なタンパク質、侵入した病原体などを特異的に識別して除去できる選択的オートファジーが存在します (共同発表:オートファジーによる小胞体分解の新規受容体を発見)。水島氏らはオートファゴソーム膜上のLC3結合タンパク質を網羅的に解析することで、小胞体膜に存在するTEX264が小胞体の選択的分解(ERファジー)に関与する受容体であることを突き止めました (共同発表:オートファジーによる小胞体分解の新規受容体を発見) (共同発表:オートファジーによる小胞体分解の新規受容体を発見)。この成果は、オートファジーが細胞内の特定の構造を狙い撃ちで分解する仕組みを分子レベルで示したものであり、国際的にも大きな注目を集めました。こうした日本発の研究は、オートファジーが多彩な生理機能を持つことを次々に明らかにし、世界の関連研究を先導しています。
さらに、日本ではオートファジー研究を推進するための組織的な取り組みも行われています。2010年代には文部科学省の主導でオートファジーをテーマとした新学術領域研究が発足し、国内の研究者コミュニティが連携して基礎から応用まで幅広い研究を展開しました。また、大阪大学や東京工業大学などにオートファジー研究センターが設立されるなど、研究環境の整備も進んでいます。これらの努力により、日本はオートファジー研究において量・質ともに世界トップクラスの水準を維持しており、「オートファジーと言えば日本」という評価が定着しています。
3. オートファジーと疾患の関係
オートファジーは細胞の自己防衛・品質管理機構であるため、その破綻や過剰は様々な疾患と密接に関わります (Autophagy – Wikipedia)。ここでは、特に注目される分野である老化, 神経変性疾患, がん, 免疫について、オートファジーとの関係を解説します。
老化
加齢に伴い、細胞のオートファジー能力は徐々に低下することが知られています ( Autophagy – An Emerging Anti-Aging Mechanism – PMC )。老化細胞では不要なタンパク質の凝集体や損傷ミトコンドリアなどの“老廃物”が蓄積しますが、オートファジー低下はそれらの除去不全を招き、細胞機能の衰えを加速させると考えられます ( Autophagy – An Emerging Anti-Aging Mechanism – PMC )。実際、出芽酵母・線虫・ショウジョウバエ・マウスといったモデル生物では、オートファジー関連遺伝子を欠損させると寿命が短縮し、逆にオートファジーを活性化させる操作により寿命延長効果が認められています (Autophagy: The recycling and repair process within cells has enormous potential to help fight aging-related diseases – https://debuglies.com) (Autophagy: The recycling and repair process within cells has enormous potential to help fight aging-related diseases – https://debuglies.com)。例えば、ショウジョウバエでオートファジー促進因子Atg1やAtg8を過剰発現すると寿命が著しく延び、老齢個体で見られるタンパク質凝集の蓄積が軽減されることが報告されています (Autophagy: The recycling and repair process within cells has enormous potential to help fight aging-related diseases – https://debuglies.com)。さらに、哺乳類でもmTOR経路阻害剤ラパマイシン(オートファジーを誘導)を高齢マウスに投与すると寿命が延びることが示されています (Autophagy: The recycling and repair process within cells has enormous potential to help fight aging-related diseases – https://debuglies.com)。このような知見から、オートファジーは“アンチエイジング”の要となる細胞機構の一つと目されています。
興味深いことに、カロリー制限(摂取カロリーを抑える食事)は古くから寿命延長効果が知られていますが、その作用機序の一端にオートファジー誘導があると考えられています (Autophagy: The recycling and repair process within cells has enormous potential to help fight aging-related diseases – https://debuglies.com)。カロリー制限や断続的断食により細胞内でオートファジーが活性化し、老化の原因となる分子・細胞レベルのダメージが除去されやすくなるためと推測されています。実際、カロリー制限下の長寿マウスではオートファジー活性が高く保たれていることや、オートファジーができない変異マウスではカロリー制限の効果が減弱することが報告されています (Autophagy: The recycling and repair process within cells has enormous potential to help fight aging-related diseases – https://debuglies.com) ( Autophagy – An Emerging Anti-Aging Mechanism – PMC )。以上のように、老化抑制・寿命延長においてオートファジーは不可欠であり、「オートファジーを促進すれば老化を遅らせられるのではないか」という視点から、創薬や健康法への応用研究も活発化しています(後述)。


神経変性疾患
アルツハイマー病やパーキンソン病に代表される神経変性疾患では、脳神経細胞内に不要なタンパク質の凝集体が蓄積し、神経細胞死と機能障害を引き起こします。オートファジーはこうした異常タンパク質を除去する主要な経路であるため、その機能低下は病態に直結します (Autophagy: The recycling and repair process within cells has enormous potential to help fight aging-related diseases – https://debuglies.com)。実際、「オートファジーの低下はアルツハイマー病・パーキンソン病発症の一因となる」と現在では広く考えられています (世界中が注目 ノーベル賞受賞の「オートファジー」 – ResOU)。
パーキンソン病(PD)では、異常凝集したαシヌクレインというタンパク質(レヴィ小体の主成分)が神経細胞内に蓄積します。CMAは本来、αシヌクレインのような可溶性タンパク質を選択的に分解する経路ですが、変異型αシヌクレイン(A53TやA30P変異)はCMAによる分解がうまくいかず、リソソーム受容体LAMP2Aを詰まらせて他の基質タンパク質の分解も阻害してしまうことが分かっています (File:Autophagy.jpg – Wikimedia Commons)。その結果、細胞は補償的にマクロオートファジーを活性化しますが、それでも処理しきれない凝集体が蓄積して神経細胞を傷害すると考えられます (File:Autophagy.jpg – Wikimedia Commons)。このような知見から、近年ではCMAを人為的に活性化してαシヌクレインを効果的に除去できないかというアプローチが模索されています。実験レベルでは、CMAを亢進させる化合物の投与によりモデルマウスで運動機能の改善が見られるとの報告もあり、CMA活性化は新たなパーキンソン病治療戦略となり得ることが示唆されています (CMA as a Means to Counteract Alpha-synuclein Pathology in Non …)。また、パーキンソン病の一部はPINK1やParkinといった遺伝子の変異で起こりますが、これらは損傷ミトコンドリアを選択的に除去するマイトファジー(ミトコンドリアのオートファジー)の経路に関わる因子であり、やはりオートファジーシステムの破綻が病因に直結する例といえます (Autophagy – Wikipedia)。
アルツハイマー病(AD)でも、異常リン酸化タウタンパク質の凝集やAβペプチドの蓄積に対し、オートファジーが重要なクリアランス経路になります。AD患者脳ではオートファゴソーム様構造体が蓄積しリソソームとの融合障害が示唆されること、オートファジー関連遺伝子の発現低下が報告されていることなど、オートファジー機能不全の関与が示唆されています (Autophagy: The recycling and repair process within cells has enormous potential to help fight aging-related diseases – https://debuglies.com)。他方、ADモデルマウスではオートファジーを促進する処置により病理の軽減が図れる場合があり、こちらもオートファジー促進による治療が研究されています。例えば、mTOR阻害薬ラパマイシンやその誘導体の投与によってマウス脳内のAβ凝集体が減少し認知機能が改善するとの報告や、ポリアミンの一種スペルミジンの投与によって変性タンパク質の分解が促進され加齢に伴う記憶障害が緩和されたとの報告があります (Autophagy: The recycling and repair process within cells has enormous potential to help fight aging-related diseases – https://debuglies.com)。スペルミジンは安全性の高い天然化合物として注目されており、オートファジー活性化による認知症予防効果が期待されています。
このように、オートファジーと神経変性疾患は表裏一体の関係にあります。オートファジーの低下が疾患を悪化させ、一方でオートファジーを適切に操作すれば病的タンパク質の蓄積を防ぎうるため、創薬の有望なターゲットとなっています。今後、アルツハイマー病・パーキンソン病をはじめとする神経難病に対して、オートファジー経路を標的にした治療法が実用化される可能性があります。




がん治療
オートファジーはがん(悪性腫瘍)の発生・進行とも複雑な関係を持ちます。一般に、適度なオートファジーは細胞内環境をクリーンに保つことで遺伝子変異やがん化を抑制する腫瘍抑制因子的な役割を果たします (Autophagy – Wikipedia)。実際、オートファジー関連遺伝子Beclin1の発現低下が一部のがんで見られることや、オートファジー不全マウスで肝腫瘍が発生しやすいことが報告されています。このように**「オートファジーはがん化を防ぐ」**側面がある一方で、ひとたび細胞ががん化して腫瘍が形成されると、今度はオートファジーががん細胞の生存を助けてしまうケースが多々あります (Autophagy – Wikipedia)。
急速に増殖するがん細胞は、栄養や酸素が乏しい環境下でも生き延びる必要があります。そのストレスに対抗する手段の一つとして、がん細胞は自己消化でエネルギーや材料を捻出するオートファジーを活発化させます (Autophagy – Wikipedia)。例えば、腫瘍内部の低酸素・栄養飢餓状態においてオートファジーがスイッチオンになると、細胞内リサイクルによってATPなどエネルギー供給が維持され、がん細胞は死なずに増殖を続けられます (Autophagy – Wikipedia)。さらに、放射線治療や抗がん剤によるダメージから逃れるためにもオートファジーが利用されることが知られています (Autophagy – Wikipedia)。実際、ある種のがん細胞にマイクロRNAを導入してオートファジーを誘導すると放射線耐性が上昇しますが、その状態でオートファジー関連遺伝子を阻害するとがん細胞の死滅が促進されるとの報告があります (Autophagy – Wikipedia)。このように、**「進行がんにおいてオートファジーは細胞死を防ぎ、生存を助ける」**プロセスになり得るのです。
以上を踏まえ、現在のがん研究・治療ではオートファジーの抑制が一つの戦略として注目されています。すなわち、がん細胞が生き延びる“逃げ道”であるオートファジーを塞ぐことで、通常なら死なないがん細胞を死に追いやったり、抗がん剤への感受性を高めたりしようという試みです (Autophagy – Wikipedia)。例えば、マウスの腫瘍モデルではオートファジー関連遺伝子Atg5やAtg7を欠損させると腫瘍細胞の増殖が停止し、生存期間が延長することが示されています (Autophagy – Wikipedia)。また、クロロキンやヒドロキシクロロキンといった既存薬剤はリソソームの酸性環境を中和して結果的にオートファジー最終段階(分解)を阻害する作用があり、これらを抗がん剤と組み合わせて投与する臨床試験が世界各地で行われています (東京大学 水島 昇 先生より 『オートファジー研究の現状と今後の展開』 | MBLライフサイエンス)。実際に進行がん患者を対象にした予備的な臨床研究では、従来治療にヒドロキシクロロキンを併用することで治療効果の改善が報告されたケースもあり、メタ解析でもオートファジー阻害薬併用群の方が有意に腫瘍縮小効果が高かったとの結果が得られています (The clinical value of using chloroquine or hydroxychloroquine as …)。こうした成果を受け、現在進行中の臨床試験ではヒドロキシクロロキン併用療法の安全性・有効性が精力的に検証されています (東京大学 水島 昇 先生より 『オートファジー研究の現状と今後の展開』 | MBLライフサイエンス)。
もっとも、オートファジーは正常細胞にとっても重要なプロセスであるため、その阻害は副作用リスクも伴います (Autophagy – Wikipedia)。実際、オートファジーを無理に止めると細胞死ではなく別経路での生存につながってしまう可能性や、正常組織へのダメージが懸念されるという指摘もあります (Autophagy – Wikipedia)。したがって、がん治療におけるオートファジー操作はきわめて慎重な最適化が求められます。現在は、どのようながん種・病期でオートファジーを抑制すべきか、あるいは逆に誘導すべきか(※一部ではオートファジー誘導により腫瘍抑制を狙う戦略も研究されています (Autophagy – Wikipedia))など、症例に応じたアプローチが模索されている段階です。将来的には、腫瘍細胞の状態を見極めて**「オートファジーのブレーキ」と「アクセル」を使い分ける**オーダーメイド治療が実現するかもしれません。
免疫機能
オートファジーは私たちの免疫システムとも深く関係しています (Autophagy – Wikipedia)。一つは細胞レベルでの感染防御への寄与です。細胞内に侵入した細菌やウイルスを自食作用で取り込み、リソソームで分解処理してしまう現象は「ゼノファジー(異物オートファジー)」と呼ばれ、自然免疫の一環として働きます (Autophagy – Wikipedia)。例えば、細菌が細胞内の液胞(食胞)を破って逃げ出した際、細胞はガレクチン8というセンサー分子で破れた膜を検知し (Autophagy – Wikipedia)、そこにオートファジーアダプタータンパク質(NDP52など)を集積させて付着した細菌をオートファゴソームへと誘導します (Autophagy – Wikipedia)。こうして隔離された細菌はリソソーム酵素で分解され、増殖を阻止されます (Autophagy – Wikipedia)。結核菌やサルモネラ菌などの病原体に対し、宿主細胞がオートファジー網を駆使して対抗する様子が明らかにされており、ゼノファジーは細胞の「自衛隊」とも言える機構です。また近年、オートファジーは侵入病原体の情報を免疫系に伝える役割も持つことが判明してきました。オートファゴソームで分解された細菌由来抗原が抗原提示経路に乗り、獲得免疫(T細胞など)を活性化する手助けをすることも報告されています。このように、オートファジーは単なる分解装置に留まらず、免疫応答全体を調節する働きをも担っているのです (Autophagy – Wikipedia)。
さらに、オートファジーは炎症反応の制御にも関与します。過剰な炎症は自己組織を傷つけるため、生体には炎症を終息させる仕組みが必要ですが、オートファジーは炎症誘導経路の分子(炎症性サイトカインやその前駆体など)を分解したり、逆に炎症を促進するシグナル経路を抑えたりすることで、炎症の暴走を防いでいます (Autophagy – Wikipedia)。オートファジー関連遺伝子の変異が炎症性腸疾患(クローン病など)の発症リスクとなることや、自己免疫疾患でオートファジーの異常が見られることが報告されており、免疫とオートファジーの密接なつながりが示唆されています。興味深い例として、免疫記憶(病原体に対する長期防御力)の維持にもオートファジーが必要であることが判明しています。加齢に伴いメモリーT細胞でオートファジー活性が低下し、それが高齢者でのワクチン応答低下や易感染性に関与すると考えられています (Autophagy: The recycling and repair process within cells has enormous potential to help fight aging-related diseases – https://debuglies.com)。実際、ヒト高齢者由来のT細胞にスペルミジンを投与してオートファジーを回復させると、若年者と同程度の免疫応答能が蘇ることが報告されました (Autophagy: The recycling and repair process within cells has enormous potential to help fight aging-related diseases – https://debuglies.com)。このように、オートファジーは免疫系の健全な働きを裏で支える不可欠なプロセスであり、その破綻は感染症や炎症疾患、自己免疫疾患の一因となり得ます。

4. 応用研究と医療・創薬分野への展開
オートファジーの理解が深まるにつれ、そのメカニズムを操作して病気を治療しようという応用研究が盛んになっています (東京大学 水島 昇 先生より 『オートファジー研究の現状と今後の展開』 | MBLライフサイエンス)。基礎研究の段階から、臨床応用を見据えた取り組みまで、いくつかの重要な方向性があります。
● オートファジーを標的とした新規治療薬の開発: がん領域で述べたように、オートファジーを抑制する薬剤(例えばクロロキンやヒドロキシクロロキン)は既に臨床試験で利用が始まっています (東京大学 水島 昇 先生より 『オートファジー研究の現状と今後の展開』 | MBLライフサイエンス)。これらは本来マラリア薬や抗炎症薬として使われてきましたが、腫瘍細胞のオートファジー活性を低下させて抗がん剤の効果を高める目的で再利用されています。現在、アメリカや日本を含む複数の国で臨床研究が進行中であり、いくつかの固形がんで有望な結果が報告されつつあります (東京大学 水島 昇 先生より 『オートファジー研究の現状と今後の展開』 | MBLライフサイエンス)。一方、神経変性疾患などでは逆にオートファジーを促進する薬剤の探索が行われています。例えば、アルツハイマー病モデルで効果のあったラパマイシンは免疫抑制剤として既に使われていますが、これを認知症治療に転用できないか検討が進められています (Autophagy: The recycling and repair process within cells has enormous potential to help fight aging-related diseases – https://debuglies.com)。また、シャペロン介在性オートファジー(CMA)を活性化する低分子化合物のスクリーニング研究なども報告されており、パーキンソン病などへの応用が期待されています (CMA as a Means to Counteract Alpha-synuclein Pathology in Non …)。さらに、最近ではオートファジー経路の特定段階(例えばオートファゴソーム形成や選択的オートファジーの受容体)を狙った新規薬剤の開発も活発化してきました。創薬企業やアカデミアが協力し、**「オートファジーを制御する新薬」**の実現に向けた研究開発が世界的に加速しています。
● アンチエイジング・健康分野への応用: オートファジーは細胞レベルの老化防止機構であるため、加齢に伴う体の変化を緩和し健康寿命を延ばすターゲットとしても注目されています。近年の研究で、適度な運動や断食(ファスティング)がオートファジーを活性化し、組織の若返りに寄与する可能性が示唆されました (Autophagy: The recycling and repair process within cells has enormous potential to help fight aging-related diseases – https://debuglies.com)。例えばマウスに断続的断食を行わせると心臓や腎臓でオートファジー関連因子が増加し、臓器機能の維持に役立つとの報告があります。また、先述のスペルミジンはヒトでの摂取量が多い人ほど寿命が延びるという疫学研究もあり、オートファジー促進を介した効果ではないかと考えられています。こうした知見から、サプリメントや機能性食品の分野でも「オートファジー促進」を謳う素材が登場しています。例えば、緑茶に含まれるポリフェノール(カテキン)がオートファジーを誘導する可能性や、発酵大豆食品中の成分が寿命延長効果を示す場合にオートファジーが関与するといった報告があります。ただし、ヒトで明確にアンチエイジング効果をもたらすオートファジー誘導法はまだ確立しておらず、現在進行形の研究課題です。今後、老化関連疾患(認知症、サルコペニア、生活習慣病など)を予防・改善する目的で、安全かつ効果的にオートファジーを調節する医療・ヘルスケア技術が開発されることが期待されます。
● その他の分野への波及: オートファジー研究はこの他にも、再生医療や臓器移植(臓器の保存中に起こる劣化を抑える研究)、感染症治療(細胞のオートファジー機能を高めてウイルス増殖を抑制する戦略)、さらには農業(作物の老化制御)や宇宙生物学(長期宇宙滞在での細胞恒常性維持)など、極めて広範な応用可能性を持っています。基礎的な細胞現象の解明からスタートしたオートファジー研究ですが、その波及効果は計り知れず、21世紀のライフサイエンスにおけるキーテクノロジーの一つになると予想されています。


5. まとめと今後の展望
本記事では、オートファジーの基礎から最新研究動向まで、日本の貢献を交えて概観しました。オートファジーは細胞のゴミ処理とリサイクルを担う重要なプロセスであり、その解明により生命現象の基本原理が明らかになるとともに、様々な疾患の理解と治療に新たな道が開けています。日本人研究者は大隅良典氏のノーベル賞受賞に象徴されるように、この分野で世界をリードしてきました。今後も日本発の独創的なアイデアと技術力で、オートファジー研究のフロンティアを切り拓いていくことが期待されます。
オートファジー研究の未来にはいくつかの重要な方向性が見えています。一つは、オートファジーの更なる分子メカニズムの深化です。オートファジーに関わる遺伝子は既に数十種類知られていますが、例えば選択的オートファジーが標的を識別する仕組みや、オートファジーと他の細胞内経路(ユビキチン-プロテアソーム系や細胞死経路)とのネットワークなど、未解明の課題が残されています。それらを解き明かすことで、細胞内の品質管理システムの全貌がより鮮明になるでしょう。二つ目は、疾患へのトランスレーション(橋渡し)研究です。基礎研究で得られた知見をもとに、創薬・治療法の開発や疾患バイオマーカーの探索を進めることが重要です (東京大学 水島 昇 先生より 『オートファジー研究の現状と今後の展開』 | MBLライフサイエンス)。幸い、オートファジーは培養細胞やモデル生物で評価しやすい指標が整っており、創薬標的として「扱いやすい」面があります。今後、製薬企業との連携や産学官の協力体制のもと、より多くの臨床試験が行われ、有望な成果が生まれることが期待されます。
また、オートファジー研究は今や分子生物学・医学の枠を超えて、学際的な広がりを見せています。計算機科学・人工知能(AI)を用いたビッグデータ解析でオートファジー制御ネットワークを解読したり、工学的手法で細胞内オルガネラを人工的に操作してオートファジーを制御する、といった新分野融合的な試みも登場しています。こうした異分野との連携により、オートファジー研究はさらに革新的な展開を遂げるでしょう。
最後に強調したいのは、オートファジー研究における国際協調と人材育成の重要性です。日本が世界をリードしてきたとはいえ、グローバルな競争・協力はますます激しくなっています。若手研究者の育成や国際共同研究プロジェクトへの参画を通じて、日本発の知見をグローバルスタンダードへと昇華させていくことが求められます。幸い、日本にはオートファジー研究に情熱を注ぐ次世代が育ちつつあり、その活動は国内外で高い評価を受けています。今後、日本が果たすべき役割は、培ってきた知見とネットワークを最大限に活用し、オートファジー研究の新たな地平を切り開くことです。それはひいては、人類の健康と福祉に大きく貢献する道でもあります。
革新的な発見が相次ぐオートファジー研究は、まさに「衝撃」をもって我々に生命の深遠な仕組みを教えてくれています。その衝撃を原動力に、日本発のサイエンスがこれからも世界をリードし続けることを期待しましょう。
参考文献・情報源:
【1】 Autophagy – Wikipedia (Autophagy – Wikipedia) (Autophagy – Wikipedia)
【2】 Autophagy – Wikipedia (Autophagy – Wikipedia)
【4】 Autophagy – Wikipedia (Autophagy – Wikipedia)
【8】 オートファジー-ノーベル賞を受賞した大隅栄誉教授の研究とは – 東京工業大学ニュース (オートファジー-ノーベル賞を受賞した大隅栄誉教授の研究とは | 東工大ニュース | 東京工業大学) (オートファジー-ノーベル賞を受賞した大隅栄誉教授の研究とは | 東工大ニュース | 東京工業大学) (オートファジー-ノーベル賞を受賞した大隅栄誉教授の研究とは | 東工大ニュース | 東京工業大学)
【9】 世界中が注目 ノーベル賞受賞の「オートファジー」 – 大阪大学 ResOU (世界中が注目 ノーベル賞受賞の「オートファジー」 – ResOU) (世界中が注目 ノーベル賞受賞の「オートファジー」 – ResOU)
【11】 世界中が注目 ノーベル賞受賞の「オートファジー」 – 大阪大学 ResOU (世界中が注目 ノーベル賞受賞の「オートファジー」 – ResOU)
【12】 オートファジーによる小胞体分解の新規受容体を発見 – 科学技術振興機構 プレスリリース (共同発表:オートファジーによる小胞体分解の新規受容体を発見) (共同発表:オートファジーによる小胞体分解の新規受容体を発見)
【13】 オートファジーによる小胞体分解の新規受容体を発見 – 科学技術振興機構 プレスリリース (共同発表:オートファジーによる小胞体分解の新規受容体を発見)
【16】 Autophagy – An Emerging Anti-Aging Mechanism – PMC (J Clin Exp Pathol) ( Autophagy – An Emerging Anti-Aging Mechanism – PMC )
【17】 Autophagy – An Emerging Anti-Aging Mechanism – PMC (J Clin Exp Pathol) ( Autophagy – An Emerging Anti-Aging Mechanism – PMC )
【21】 Autophagy: Recycling and repair process… – Debuglies News (Autophagy: The recycling and repair process within cells has enormous potential to help fight aging-related diseases – https://debuglies.com) (Autophagy: The recycling and repair process within cells has enormous potential to help fight aging-related diseases – https://debuglies.com) (Autophagy: The recycling and repair process within cells has enormous potential to help fight aging-related diseases – https://debuglies.com)
【22】 Chaperone-mediated autophagy as a therapeutic target in PD – Michael J. Fox Foundation (CMA as a Means to Counteract Alpha-synuclein Pathology in Non …)
【30】 Autophagy – Wikipedia (Autophagy – Wikipedia) (Autophagy – Wikipedia) (Autophagy – Wikipedia)
【34】 Autophagy – Wikipedia (Autophagy – Wikipedia)
【40】 オートファジー研究の現状と今後の展開 – MBLライフサイエンス 特別寄稿 水島昇 (東京大学 水島 昇 先生より 『オートファジー研究の現状と今後の展開』 | MBLライフサイエンス)